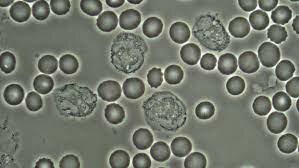
Microscopía de contraste

-
 El microscopio fue inventado por Zacharias Janssen en 1590.
El microscopio fue inventado por Zacharias Janssen en 1590. -
 Pero en 1607 Anton van Leeuwenhoek presenta un microscopio con que se puede ver en mejor calidad que el de HH Janssen.
Pero en 1607 Anton van Leeuwenhoek presenta un microscopio con que se puede ver en mejor calidad que el de HH Janssen. -
 En 1665 aparece en la obra de William Harvey sobre la circulación sanguínea al mirar al microscopio los capilares sanguíneos, y Robert Hooke publicó su obra Micrographia.
En 1665 aparece en la obra de William Harvey sobre la circulación sanguínea al mirar al microscopio los capilares sanguíneos, y Robert Hooke publicó su obra Micrographia.
En 1665 Robert Hooke observó con un lente un delgado corte de corcho y notó que el material era poroso; contenía cavidades poco profundas a modo de celditas a las que llamó células. -
-
 Richard Adolf Zsigmondy inventa el ultramicroscopio. Este tipo de microscopio permite observar muestras con mejores resoluciones que las del microscopio óptico.
Richard Adolf Zsigmondy inventa el ultramicroscopio. Este tipo de microscopio permite observar muestras con mejores resoluciones que las del microscopio óptico. -
 August Köhler y Moritz von Rohr desarrollan el microscopio de luz ultravioleta.
August Köhler y Moritz von Rohr desarrollan el microscopio de luz ultravioleta. -
 Leitz empieza a comercializar el primer microscopio binocular plenamente funcional desarrollado por Felix Jentzsch.
Leitz empieza a comercializar el primer microscopio binocular plenamente funcional desarrollado por Felix Jentzsch. -
 Leitz empieza a comercializar el primer microscopio binocular plenamente funcional desarrollado por Felix Jentzsch.
Leitz empieza a comercializar el primer microscopio binocular plenamente funcional desarrollado por Felix Jentzsch. -
 Ernst Ruska, junto con el ingeniero Max Knoll construye el primer prototipo del microscopio electrónico de transmisión.
Ernst Ruska, junto con el ingeniero Max Knoll construye el primer prototipo del microscopio electrónico de transmisión. -
 Ernst Ruska, junto con el ingeniero Max Knoll construye el primer prototipo del microscopio electrónico de transmisión.
Ernst Ruska, junto con el ingeniero Max Knoll construye el primer prototipo del microscopio electrónico de transmisión. -
 Frits Zernike inventa el microscopio de contraste de fases que permite observar muestras biológicas transparentes. En 1953 recibe el premio Nobel de Física por este invento.
Frits Zernike inventa el microscopio de contraste de fases que permite observar muestras biológicas transparentes. En 1953 recibe el premio Nobel de Física por este invento. -
 Manfred von Ardenne inventa el microscopio electrónico de barrido.
Manfred von Ardenne inventa el microscopio electrónico de barrido. -
George Nomarski desarrolla la microscopía de contraste de interferencia diferencial. Esta técnica es ampliamente utilizada para observar muestras biológicas con vida.
George Nomarski desarrolla la microscopía de contraste de interferencia diferencial. Esta técnica es ampliamente utilizada para observar muestras biológicas con vida. -
 Marvin Minsky patenta el microscopio confocal.
Marvin Minsky patenta el microscopio confocal. -
 Gerd Binnig y Heinrich Rohrer inventan el microscopio de efecto túnel que permite observar superfícies a escalas atómicas. En 1986 recibieron el premio Nobel de Física junto con Ernst Ruska.
Gerd Binnig y Heinrich Rohrer inventan el microscopio de efecto túnel que permite observar superfícies a escalas atómicas. En 1986 recibieron el premio Nobel de Física junto con Ernst Ruska. -
 La empresa Carl Zeiss empieza a comercializar el primer microscopio con focal láser de barrido.
La empresa Carl Zeiss empieza a comercializar el primer microscopio con focal láser de barrido.
A list shows items. A timeline shows sequence.
Use Timetoast to make dates, milestones, and turning points easier to understand in a clear visual format. Timetoast is a timeline maker for work, school, research, and stories.
